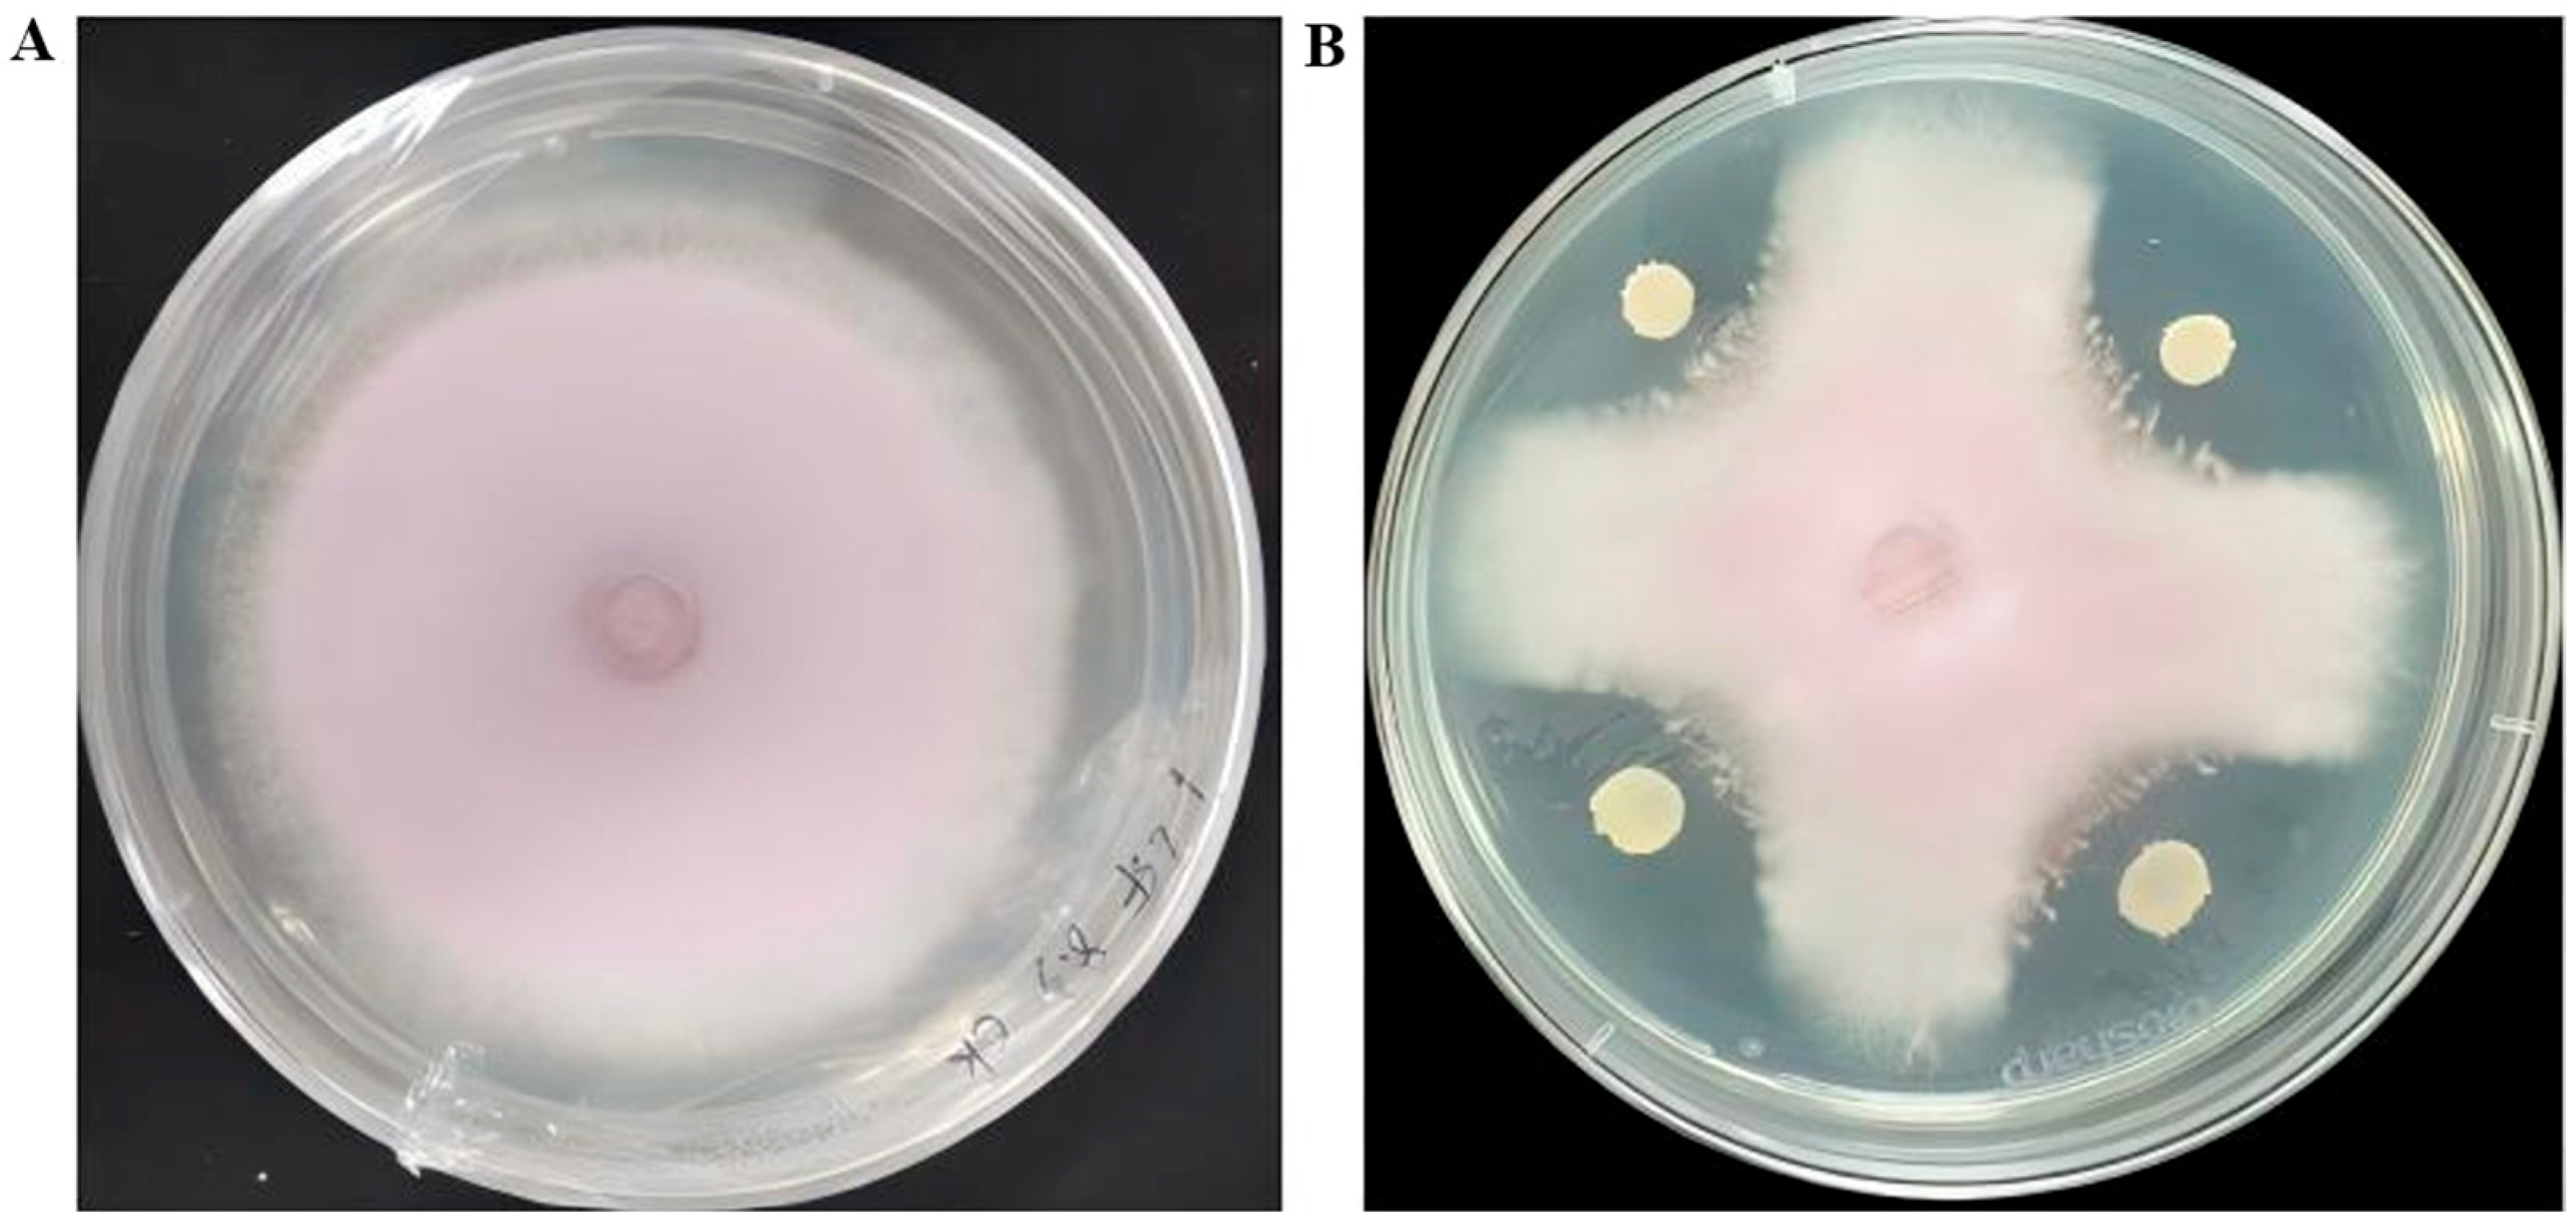

Screening and Genomic Analysis of Bacillus velezensis R12 as a Biocontrol Agent Against Fusarium oxysporum Causing Wilt in Longya Lily (Lilium brownii var. viridulum)
Abstract
1. Introduction
2. Materials and Methods
2.1. Soil Sampling and Bacterial Isolation
2.2. Screening of Antagonistic Bacteria
2.3. Inhibitory Effect of Strain R12 Bacterial Culture Filtrate (BCF) on Spore Morphology and Hyphal Growth of Fol L1-1
2.4. Scanning Electron Microscopy of Strain R12
2.5. Greenhouse Biocontrol Efficacy of Strain R12 Against Longya Lily Fusarium Wilt
2.6. Plant Growth-Promoting (PGP) Trait Analysis of Strain R12
2.7. Identification of Antagonistic Bacteria R12
2.8. Genome Sequencing and Assembly of Strain R12
2.9. Genomic Functional Annotation of Strain R12
2.10. Analysis of Gene Clusters Responsible for the Biosynthesis of Secondary Metabolites
2.11. Statistical Analyses
3. Results
3.1. Isolation and Screening of Antagonistic Bacteria Against Fusarium oxysporum
3.2. Antagonistic Activity of Strain R12 BCF Against Fol L1-1
3.3. Physiology, Biochemistry, and 16S rRNA Gene Identification of Antagonistic Bacterial Strain R12
3.4. Assessment of PGP Traits in B. velezensis R12
3.5. Effects of B. velezensis R12 on Fusarium Wilt Suppression and Growth Promotion in Longya Lily
3.6. Genome Sequencing and Assembly of R12
3.7. Functional Annotation of the Genome of R12
3.8. Annotation Results Description of the Nr Database
3.9. Description of GO Database Annotation Results
3.10. Annotation Results Description of the eggNOG Database
3.11. Genomic Analysis of Antimicrobial Biosynthetic Potential in R12
4. Discussion
5. Conclusions
Supplementary Materials
Author Contributions
Funding
Institutional Review Board Statement
Informed Consent Statement
Data Availability Statement
Conflicts of Interest
References
- Li, X.; Wang, Z.; Hou, C.; Gong, X.; Liu, Z.; Shi, Y.; Yan, J.; Tong, Q. Identification and Characterization of Volatile Organic Compounds Based on GC-IMS Technology in Different Organs of Lilium brownii var. viridulum and After Bud-Removal and Non-Bud-Removal Treatments. Molecules 2025, 30, 1238. [Google Scholar] [CrossRef]
- He, D.; Zhang, H.; Li, S.; Zhou, X.; Zhang, S.H. Research progress on chemical constituents and pharmacological effects of Baihe (Lilii bulbus) and predictive analysis on quality markers. Chin. Arch. Tradit. Chin. Med. 2022, 40, 205–212. [Google Scholar]
- Zhou, J.; An, R.; Huang, X. Genus Lilium: A review on traditional uses, phytochemistry and pharmacology. J. Ethnopharmacol. 2021, 270, 113852. [Google Scholar] [CrossRef]
- Baayen, R.; Rijkenberg, F. Fine structure of the early interaction of lily roots with Fusarium oxysporum f. sp. lilii. Eur. J. Plant Pathol. 1999, 105, 431–443. [Google Scholar] [CrossRef]
- Liu, C.; Wang, Y.; Jin, L.; Wang, Y.; Liu, D. Morphological, molecular, and biological characterization of bulb rot pathogens in stored Lanzhou lily and the in vitro antifungal efficacy of three plant essential oils. Front. Microbiol. 2024, 15, 1307966. [Google Scholar] [CrossRef] [PubMed]
- Michielse, C.B.; Rep, M. Pathogen profile update: Fusarium oxysporum. Mol. Plant Pathol. 2009, 10, 311–324. [Google Scholar] [CrossRef]
- Liang, L.; Liu, S.; Zhu, D.; Huang, Y.; Zheng, Q.; Ji, H.; Zhan, M.; Chen, M. The identification of pathogens of bulb rot of Lilium browni var. viridulum and screening of antagonistic bacteria. J. Jiangxi Norm. Univ. 2024, 48, 491–498. [Google Scholar] [CrossRef]
- Al-Hazmi, N.E. Antibacterial and anticancer activities of rhizobacterial lipopeptides against carcinogenic bacteria. Antonie Van Leeuwenhoek 2025, 118, 118. [Google Scholar] [CrossRef] [PubMed]
- Xu, W.; Yang, Q.; Yang, F.; Xie, X.; Goodwin, P.H.; Deng, X.; Tian, B.; Yang, L. Evaluation and Genome Analysis of Bacillus subtilis YB-04 as a Potential Biocontrol Agent Against Fusarium Wilt and Growth Promotion Agent of Cucumber. Front. Microbiol. 2022, 13, 885430. [Google Scholar] [CrossRef]
- Cao, Y.; Pi, H.; Chandrangsu, P.; Li, Y.; Wang, Y.; Zhou, H.; Xiong, H.; Helmann, J.D.; Cai, Y. Antagonism of Two Plant-Growth Promoting Bacillus velezensis Isolates Against Ralstonia solanacearum and Fusarium oxysporum. Sci. Rep. 2018, 8, 4360. [Google Scholar] [CrossRef] [PubMed]
- Fan, B.; Chen, X.H.; Budiharjo, A.; Bleiss, W.; Vater, J.; Borriss, R. Efficient colonization of plant roots by the plant growth promoting bacterium Bacillus amyloliquefaciens FZB42, engineered to express green fluorescent protein. J. Biotechnol. 2011, 151, 303–311. [Google Scholar] [CrossRef] [PubMed]
- Ramírez, V.; Martínez, J.; Bustillos-Cristales, M.D.R.; Catañeda-Antonio, D.; Munive, J.A.; Baez, A. Bacillus cereus MH778713 elicits tomato plant protection against Fusarium oxysporum. J. Appl. Microbiol. 2022, 132, 470–482. [Google Scholar] [CrossRef]
- Li, B.; Wan, J.; Sha, J.; Tian, M.; Wang, M.; Zhang, X.; Sun, W.; Mao, Y.; Min, J.; Qin, Y.; et al. Genomics assisted functional characterization of Bacillus velezensis E as a biocontrol and growth promoting bacterium for lily. Front. Microbiol. 2022, 13, 976918. [Google Scholar] [CrossRef]
- Nautiyal, C.S. An efficient microbiological growth medium for screening phosphate solubilizing microorganisms. FEMS Microbiol. Lett. 1999, 170, 265–270. [Google Scholar] [CrossRef]
- Schwyn, B.; Neilands, J.B. Universal chemical assay for the detection and determination of siderophores. Anal. Biochem. 1987, 160, 47–56. [Google Scholar] [CrossRef]
- Glickmann, E.; Dessaux, Y. A critical examination of the specificity of the salkowski reagent for indolic compounds produced by phytopathogenic bacteria. Appl. Environ. Microbiol. 1995, 61, 793–796. [Google Scholar] [CrossRef] [PubMed]
- Blin, K.; Shaw, S.; Steinke, K.; Villebro, R.; Ziemert, N.; Lee, S.Y.; Medema, M.H.; Weber, T. antiSMASH 5.0: Updates to the secondary metabolite genome mining pipeline. Nucleic Acids Res. 2019, 47, W81–W87. [Google Scholar] [CrossRef] [PubMed]
- Stannius, R.O.; Fusco, S.; Cowled, M.S.; Kovács, Á.T. Surfactin accelerates Bacillus subtilis pellicle biofilm development. Biofilm 2025, 9, 100249. [Google Scholar] [CrossRef]
- Xiao, P.; Tian, X.; Zhu, P.; Xu, Y.; Zhou, C. The use of surfactin in inhibiting Botrytis cinerea and in protecting winter jujube from the gray mold. AMB Express 2023, 13, 37. [Google Scholar] [CrossRef]
- Krishnan, N.; Velramar, B.; Velu, R.K. Investigation of antifungal activity of surfactin against mycotoxigenic phytopathogenic fungus Fusarium moniliforme and its impact in seed germination and mycotoxicosis. Pestic. Biochem. Physiol. 2019, 155, 101–107. [Google Scholar] [CrossRef]
- Wang, Y.; Sun, Z.; Wang, S.; Wen, F.; Xia, Z. Surfactin: A novel Aphis gossypii killing surfactin produced by Bacillus australimaris TRM82479 of Taklamakan Desert origin. Front. Microbiol. 2025, 16, 1559495. [Google Scholar] [CrossRef]
- Vasilchenko, A.S.; Lukyanov, D.A.; Dilbaryan, D.S.; Usachev, K.S.; Poshvina, D.V.; Taldaev, A.K.; Nikandrova, A.A.; Imamutdinova, A.N.; Garaeva, N.S.; Bikmullin, A.G.; et al. Macrolactin a is an inhibitor of protein biosynthesis in bacteria. Biochimie 2025, 232, 25–34. [Google Scholar] [CrossRef]
- Islam, T.; Rabbee, M.F.; Choi, J.; Baek, K.H. Biosynthesis, Molecular Regulation, and Application of Bacilysin Produced by Bacillus Species. Metabolites 2022, 12, 397. [Google Scholar] [CrossRef]
- Jin, P.; Wang, H.; Tan, Z.; Xuan, Z.; Dahar, G.Y.; Li, Q.X.; Miao, W.; Liu, W. Antifungal mechanism of bacillomycin D from Bacillus velezensis HN-2 against Colletotrichum gloeosporioides Penz. Pestic. Biochem. Physiol. 2020, 163, 102–107. [Google Scholar] [CrossRef]
- Gu, Q.; Yang, Y.; Yuan, Q.; Shi, G.; Wu, L.; Lou, Z.; Huo, R.; Wu, H.; Borriss, R.; Gao, X. Bacillomycin D Produced by Bacillus amyloliquefaciens Is Involved in the Antagonistic Interaction with the Plant-Pathogenic Fungus Fusarium graminearum. Appl. Environ. Microbiol. 2017, 83, e01075-17. [Google Scholar] [CrossRef]
- Khan, M.S.; Gao, J.; Chen, X.; Zhang, M.; Yang, F.; Du, Y.; Moe, T.S.; Munir, I.; Xue, J.; Zhang, X. The Endophytic Bacteria Bacillus velezensis Lle-9, Isolated from Lilium leucanthum, Harbors Antifungal Activity and Plant Growth-Promoting Effects. J. Microbiol. Biotechnol. 2020, 30, 668–680. [Google Scholar] [CrossRef]
- Khanal, S.; Imran, M.; Zhou, X.G.; Antony-Babu, S. Characterization of differences in seed endophytic microbiome in conventional and organic rice by amplicon-based sequencing and culturing methods. Microbiol. Spectr. 2024, 12, e0366223. [Google Scholar] [CrossRef]
- Degani, O.; Ayoub, A.; Dimant, E.; Gordani, A. Antagonistic interactions between maize seeds microbiome species and the late wilt disease agent, Magnaporthiopsis maydis. Front. Fungal Biol. 2024, 5, 1436759. [Google Scholar] [CrossRef]
- Wei, L.; Fan, L.; Yang, C.; Jin, M.; Osei, R. Analysis of Bioactive Compounds Produced by Bacillus mojavensis ZA1 and Their Antagonistic Effect on Colletotrichum coccodes by GC-MS. Appl. Biochem. Biotechnol. 2024, 196, 4914–4933. [Google Scholar] [CrossRef]
- Kamalanathan, V.; Sevugapperumal, N.; Nallusamy, S. Antagonistic Bacteria Bacillus velezensis VB7 Possess Nematicidal Action and Induce an Immune Response to Suppress the Infection of Root-Knot Nematode (RKN) in Tomato. Genes 2023, 14, 1335. [Google Scholar] [CrossRef]
- Shuang, M.; Wang, Y.; Teng, W.; Jin, G. Isolation and identification of an endophytic bacteria Bacillus sp. K-9 exhibiting biocontrol activity against potato common scab. Arch. Microbiol. 2022, 204, 483. [Google Scholar] [CrossRef]
- Cui, L.; Yang, C.; Wang, Y.; Ma, T.; Cai, F.; Wei, L.; Jin, M.; Osei, R.; Zhang, J.; Tang, M. Potential of an endophytic bacteria Bacillus amyloliquefaciens 3–5 as biocontrol agent against potato scab. Microb. Pathog. 2022, 163, 105382. [Google Scholar] [CrossRef]
- Wu, H.; Lu, J.; Zhao, S.; Fei, J.; Qu, Z.; Zhao, M.; Yang, H. Microbial Community of Wilted Fritillaria ussuriensis and Biocontrol Effects of Bacillus tequilensis and Trichoderma koningiopsis. Biology 2024, 13, 940. [Google Scholar] [CrossRef] [PubMed]
- Tu, J.; Zhao, X.; Yang, Y.; Yi, Y.; Wang, H.; Wei, B.; Zeng, L. Two Bacillus spp. Strains Improve the Structure and Diversity of the Rhizosphere Soil Microbial Community of Lilium brownii var. viridulum. Microorganisms 2023, 11, 1229. [Google Scholar] [CrossRef]
- Liu, Y.H.; Huang, C.J.; Chen, C.Y. Evidence of induced systemic resistance against Botrytis elliptica in lily. Phytopathology 2008, 98, 830–836. [Google Scholar] [CrossRef] [PubMed]
- Yao, Y.; Wang, L.; Zhai, H.; Dong, H.; Wang, J.; Zhao, Z.; Xu, Y. Bacillus velezensis A-27 as a potential biocontrol agent against Meloidogyne incognita and effects on rhizosphere communities of celery in field. Sci. Rep. 2025, 15, 1057. [Google Scholar] [CrossRef]
- Vibha, R.; Granada, D.L.; Skariyachan, S.; Ujwal, P.; Sandesh, K. In vitro and In silico investigation deciphering novel antifungal activity of endophyte Bacillus velezensis CBMB205 against Fusarium oxysporum. Sci. Rep. 2025, 15, 684. [Google Scholar] [CrossRef]
- Zhao, X.; Zhai, Y.; Wei, L.; Xia, F.; Yang, Y.; Yi, Y.; Wang, H.; Qiu, C.; Wang, F.; Zeng, L. Isolation and identification of a novel Bacillus velezensis strain JIN4 and its potential for biocontrol of kiwifruit bacterial canker caused by Pseudomonas syringae pv. actinidiae. Front. Plant Sci. 2024, 15, 1513438. [Google Scholar] [CrossRef]
- Meng, X.; Cai, H.; Luo, Y.; Zhao, X.; Fu, Y.; Zou, L.; Zhou, Y.; Tu, M. Biocontrol Potential of Endophytic Bacillus velezensis LSR7 Against Rubber Red Root Rot Disease. J. Fungi 2024, 10, 849. [Google Scholar] [CrossRef]
- Park, H.; Lee, Y.; Balaraju, K.; Kim, J.; Jeon, Y. Characterization and Biocontrol Efficacy of Bacillus velezensis GYUN-1190 against Apple Bitter Rot. Plant Pathol. J. 2024, 40, 681–695. [Google Scholar] [CrossRef]
- Zhong, J.; Wu, X.; Guo, R.; Li, J.; Li, X.; Zhu, J. Biocontrol potential of Bacillus velezensis HG-8-2 against postharvest anthracnose on chili pepper caused by Colletotrichum scovillei. Food Microbiol. 2024, 124, 104613. [Google Scholar] [CrossRef]
- Liu, Y.; Dai, C.; Zuo, Y.; Qiao, J.; Shen, J.; Yin, X.; Liu, Y. Characterization of Siderophores Produced by Bacillus velezensis YL2021 and Its Application in Controlling Rice Sheath Blight and Rice Blast. Phytopathology 2024, 114, 2491–2501. [Google Scholar] [CrossRef] [PubMed]
- Dutilloy, E.; Arias, A.A.; Richet, N.; Guise, J.F.; Duban, M.; Leclere, V.; Selim, S.; Jacques, P.; Jacquard, C.; Clément, C.; et al. Bacillus velezensis BE2 controls wheat and barley diseases by direct antagonism and induced systemic resistance. Appl. Microbiol. Biotechnol. 2024, 108, 64. [Google Scholar] [CrossRef] [PubMed]
- Liu, F.; Chen, S.; Chen, X.; Yong, B.; He, B. Identification of chitinase from Bacillus velezensis strain S161 and its antifungal activity against Penicillium digitatum. Protein Expr. Purif. 2024, 223, 106562. [Google Scholar] [CrossRef] [PubMed]
- Teixeira, G.M.; Cordeiro Montanari, G.C.; Nicoletto, M.L.A.; da Silva, D.V.; Noriler, S.A.; de Oliveira, J.P.; da Silva Rodrigues, M.V.; Sipoli Sanches, D.; de Padua Pereira, U.; Nunes da Rocha, U.; et al. Draft genome of Bacillus velezensis CMRP6330, a suitable biocontrol agent for disease management in crops. Microbiol. Resour. Announc. 2024, 13, e0065724. [Google Scholar] [CrossRef]
- Liu, Y.; Yin, C.; Zhu, M.; Zhan, Y.; Lin, M.; Yan, Y. Comparative Genomic Analysis of Bacillus velezensis BRI3 Reveals Genes Potentially Associated with Efficient Antagonism of Sclerotinia sclerotiorum (Lib.) de Bary. Genes 2024, 15, 1588. [Google Scholar] [CrossRef]
- Zhang, Y.; Zhang, N.; Bi, X.; Bi, T.; Baloch, F.B.; Miao, J.; Zeng, N.; Li, B.; An, Y. Growth promotion on maize and whole-genome sequence analysis of Bacillus velezensis D103. Microbiol. Spectr. 2024, 12, e0114724. [Google Scholar] [CrossRef]
- Ercole, T.G.; Kava, V.M.; Petters-Vandresen, D.A.L.; Nassif Gomes, M.E.; Aluizio, R.; Ribeiro, R.A.; Hungria, M.; Galli, L.V. Unlocking the growth-promoting and antagonistic power: A comprehensive whole genome study on Bacillus velezensis strains. Gene 2024, 927, 148669. [Google Scholar] [CrossRef]

| Characteristics | Results |
|---|---|
| Gram stain | + |
| Starch hydrolysis experiment | + |
| Glucose | + |
| Arabinose | + |
| Gelatine | + |
| Hydrogen peroxide enzyme test | + |
| Indole reaction | + |
| V-P reaction | − |
| mannitol | − |
| Treatment | Disease Incidence (%) | Disease Index | Control Efficacy (%) |
|---|---|---|---|
| Fol L1-1 | 97.26 ± 0.67 a | 94.57 ± 0.51 a | |
| Fol L1-1 + 0.1% Hymexazol | 2.19 ± 0.14 b | 2.67 ± 0.13 b | 97.18 ± 0.13 a |
| Fol L1-1 + R12 | 2.68 ± 0.15 b | 3.77 ± 0.11 b | 96.01 ± 0.07 a |
| Genome | Genome Assembly | ||
|---|---|---|---|
| Number of sequences | 22,709 | Scaffold length (bp) | 4,015,523 |
| SumBase | 210,960,009 | Scaffold number | 1 |
| N50 reads length (bp) | 10,170 | Scaffold N50 (bp) | 4,015,523 |
| N90 reads length (bp) | 6141 | Scaffold N90 (bp) | 4,015,523 |
| Mean reads length (bp) | 9289 | Contig Length (bp) | 4,015,523 |
| Max length (bp) | 30,021 | GC content (%) | 46.42 |
| Mean reads quality | 33.73 | Gaps number | 0 |
Disclaimer/Publisher’s Note: The statements, opinions and data contained in all publications are solely those of the individual author(s) and contributor(s) and not of MDPI and/or the editor(s). MDPI and/or the editor(s) disclaim responsibility for any injury to people or property resulting from any ideas, methods, instructions or products referred to in the content. |
© 2025 by the authors. Licensee MDPI, Basel, Switzerland. This article is an open access article distributed under the terms and conditions of the Creative Commons Attribution (CC BY) license (https://creativecommons.org/licenses/by/4.0/).
Share and Cite
Guo, H.; Huang, Y.; Cheng, Z.; Zheng, Q.; Li, Q.; Zhan, M.; Ji, H.; Zhao, K.; Zhu, D.; Liu, S. Screening and Genomic Analysis of Bacillus velezensis R12 as a Biocontrol Agent Against Fusarium oxysporum Causing Wilt in Longya Lily (Lilium brownii var. viridulum). Microorganisms 2025, 13, 2430. https://doi.org/10.3390/microorganisms13112430
Guo H, Huang Y, Cheng Z, Zheng Q, Li Q, Zhan M, Ji H, Zhao K, Zhu D, Liu S. Screening and Genomic Analysis of Bacillus velezensis R12 as a Biocontrol Agent Against Fusarium oxysporum Causing Wilt in Longya Lily (Lilium brownii var. viridulum). Microorganisms. 2025; 13(11):2430. https://doi.org/10.3390/microorganisms13112430
Chicago/Turabian StyleGuo, Huiying, Yushan Huang, Zihan Cheng, Qinyuan Zheng, Qingxiu Li, Mengting Zhan, Hongjie Ji, Kuan Zhao, Du Zhu, and Shaofang Liu. 2025. "Screening and Genomic Analysis of Bacillus velezensis R12 as a Biocontrol Agent Against Fusarium oxysporum Causing Wilt in Longya Lily (Lilium brownii var. viridulum)" Microorganisms 13, no. 11: 2430. https://doi.org/10.3390/microorganisms13112430
APA StyleGuo, H., Huang, Y., Cheng, Z., Zheng, Q., Li, Q., Zhan, M., Ji, H., Zhao, K., Zhu, D., & Liu, S. (2025). Screening and Genomic Analysis of Bacillus velezensis R12 as a Biocontrol Agent Against Fusarium oxysporum Causing Wilt in Longya Lily (Lilium brownii var. viridulum). Microorganisms, 13(11), 2430. https://doi.org/10.3390/microorganisms13112430

